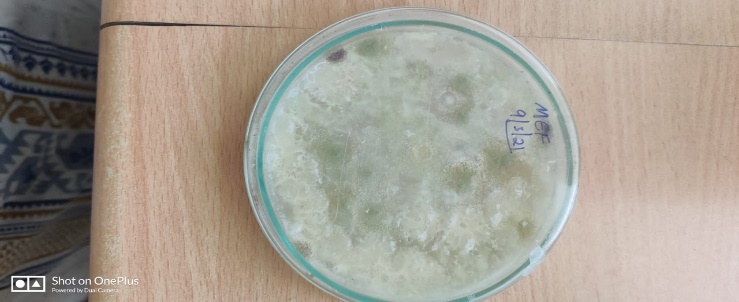

Int J Pharm Pharm Sci, Vol 15, Issue 4, 39-46Original Article
PHYTOCHEMICAL ANALYSIS AND MOLECULAR CHARACTERIZATION OF MORINGA OLEIFERA AND ITS ENDOPHYTIC FUNGI
G. DEVI PRIYANKA1, SHOBHA2, SHRUTHI S. D.3*
1Department of Biotechnology, School of Life Sciences, Garden City University, Bangalore, India, 2Department of Botany, University College, Mangaluru 575001, Karnataka, India, 3Molecular Biology and Microbiology Lab, BioEdge Solutions, Bangalore India
Email: services@bioedgesolutions.com
Received: 07 Dec 2022, Revised and Accepted: 03 Mar 2023
ABSTRAC
Objective: Moringa oleifera Lam (Moringaceae) is a highly valued plant which has an impressive range of medicinal uses with high nutritional value. Different parts of the plant were being used for the treatment of illness due to the presence of various secondary metabolites that gives the plant anti-bacterial, anti-oxidant and other properties. These secondary metabolites are synthesized by endophytic organisms, which are present inside the tissues of plant.
Methods: ITS regions were amplified using a polymerase chain reaction for molecular identification. The sequences were analysed using BLAST n and DNA barcoding of plant was done for the identification of species. The organisms were refined on Potato Dextrose stock for identification of metabolites.
Results: It was found that fungi obtained are Aspergillus fumigatus and Tricoderma turrialbense with percentage identity of 96% and 98%, respectively, as obtained from NCBI BLAST; the metabolites were extracted with ethanol extract and Flavonoids and terpenoids are the main phytoconstituents present in endophytic fungi.
Conclusion: The results obtained support the medicinal properties of plant, which gets enhanced due to the presence of endophytic fungi present in them.
Keywords: Antimicrobial activity, Enzyme production, Flavonoids, Secondary metabolites
© 2023 The Authors. Published by Innovare Academic Sciences Pvt Ltd. This is an open access article under the CC BY license (https://creativecommons.org/licenses/by/4.0/)
DOI: https://dx.doi.org/10.22159/ijpps.2023v15i4.47020. Journal homepage: https://innovareacademics.in/journals/index.php/ijpps.
INTRODUCTION
Moringa oleifera tree has a place with the group of Moringaceae, it is generally called "drumstick tree" or pony radish tree, and privately called "zogale" in Hausa, Nigeria. It was notable for its multipurpose traits, wide adoptability, and simplicity of foundation. As per its leaves, units, and blossoms were loaded with supplements critical to both human and creatures. Moringa oleifera is a local to north India however is presently found all through India. It develops vastly and reaches up to 12 m tall. The bark is dark and appears as hard cork baring in patches [1]. Moringa leaves have been accounted for to be a rich source of β-carotene, protein, vitamin C, calcium and potassium and go about as decent sources of characteristic cancer prevention agents; and subsequently upgrade the time span of usability of fat-containing food varieties because of the presence of different kinds of cell reinforcement mixtures, for example, ascorbic acid, flavonoids, phenolics and carotenoids [2, 3].

Fig. 1: Different parts of the moringa oleifera plant such as leaves, oil, seeds, flowers
Almost every one of the pieces of this plant: root, bark, gum, leaf, natural product (units), blossoms, seed and seed oil have been utilized for different infirmities in the native medication of South Asia, including the therapy of worsening and irresistible illnesses alongside cardiovascular, gastrointestinal, hematological and hepatorenal disorders [4, 3].
An endophyte is an endosymbiont, frequently an organism, which lives inside a plant for in any event part of its existence without creating any apparent sickness. They outline subtle sicknesses inside tissues of various flora for all or if not anything else a piece of their life cycle [5]. Endophytic parasites are actually mitosporic and meiosporic ascomycetes that asymptomatically dwell in the inward tissues of plants underneath the epidermal cell layer, where growths colonize living tissue by means of still infections [6]. Their organic variety is tremendous, particularly in mild and tropical rainforests. The growths are facilitated in almost 300,000 land plant species, with each plant facilitating at least one of these growths.

Fig. 2: Importance of endophytic fungi in plants
Endophytic strains have been segregated from various plants, including trees (pine and yew), grains (hay, sorghum and clover), vegetables (carrot, radish, tomatoes, yams, lettuce, and soybean), natural products (banana, pineapple, and citrus), oat grains (maize, rice, and wheat), and different harvests (sugarcane, marigold, and espresso) [7]. Additionally, endophytes involve a rich and solid wellspring of hereditary variety and organic oddity and have been applied in pharmacology (e. g., the anticancer medication taxol) and farming [8]. Endophytes are bacterial or parasitic microorganisms that colonize plant tissue intercellularly as well as intracellularly without causing any evident appearances of disease [9]. They are omnipresent, colonize in all plants, and have been disengaged from practically all plants inspected till date. Their relationship can be facultative and makes no damage to the host plants. They display complex communications with their hosts which includes mutualism and antagonism [10].
MATERIALS AND METHODS
Collection of plant material
The leaf samples of Moringa Oleifera were collected for the analysis from Garden City University Bangalore with Voucher No. P201201. The symptomless and clearly solid leaves were gathered in pre-sanitized polythene packs. The samples were collected and brought to the laboratory, where they were sterilized and stored at 4 ᵒC. Later, they have been used for the plant genomic DNA extraction and also to isolate endophytic fungi within 48 h of collection.
Preparation of plant extracts
The Moringa oleifera leaves were homogenized by adding the 10% ethanol to it. Metabolite was extracted by solvent extraction method utilizing ethyl acetate and methanol as natural solvents.
DNA isolation from plant
The genomic DNA of the plant was isolated using the CTAB method. Around 0.05 gm Moringa oleifera leaves were collected. The leaves were ground with 750 μl of extraction buffer (100 Mm Tris, 1.4 M NaCl, 20 mmol EDTA, 2% CTAB). The homogenate was kept in incubation at 65 °C for 20 min. The content was allowed to cool down at room temperature and an equal volume of chloroform: isoamyl alcohol (24:1 ratio) was added and mixed gently. The mixture was centrifuged at 10,000 rpm for 10 min in a refrigerated centrifuge, the pellet was discarded and the supernatant was transferred to another fresh microtube to which an equal volume of ice-cold isopropanol was added. This mixture was also centrifuged at 10,000 rpm for 10 min in a refrigerated centrifuge. The supernatant was discarded and 500μl of 70% ethanol was added to the pellet, followed by a quick spin at 10,000 rpm for 10 min in a refrigerated centrifuge. The supernatant was discarded and pellet was retained, which was allowed to dry for about 45 min, and then dissolved in 10μl TE buffer. This DNA was treated with RNAse and column purified to get rid of impurities [11].
Electrophoresis of the isolated DNA
The isolated plant DNA was later subjected to electrophoresis for proper quantification. Then 0.8 % agarose solution in 1 X TAE buffer was prepared for 100 ml solution is heated in oven to dissolve agarose completely. Then it is cooled to 400 ℃, and Ethidium bromide solution (0.1 g/ml) was added. When gel was set, the gel electrophoresis tray will be filled with 0.5 X TAE buffer, and then gel boat was placed in the tank and DNA solution was loaded. Then 2μl of the DNA solution was pipetted into a microfuge tube. Again, 2μl of Bromophenol dye is added and mixed for few seconds and loaded on gel. Gel unit will be run at 120 volts for 40 min [11].
PCR and gel purification
PCR amplification of isolated plant DNA was done using primers ITS2, MATK for plant. PCR amplification were acted in total reaction volume of 25 μl containing 12.5 μl of 2X PCR Master mix, 1 μl of forward primer and 1 μl of reverse primer and 9.5 μl of nuclease free water. DNA amplification was performed and DNA thermal cycler programmed for 35 cycles, the first step involved was heating to a temperature of 95 °C for 5 min trailed by 35 amplification cycles at 75 °C for 1 min for denaturation. The process annealing will take place in, 53 °C about 1-2 min. The temperature involved was 72 °C for 1 min for initial extension and Taq polymerase starts filling the missing nucleotides in the 3’ 5’ direction away from each of the primer and 72 °C for 8 min for final extension. The quality of PCR products was checked on 1 % agarose gel electrophoresis stained with ethidium bromide [11].
Sanger gene sequencing
The Bidirectional sequencing of PCR products were carried in Sequencer-Applied Biosystems (Hitachi) 3130x1 Genetic Analyzer. The data from the sequencer was taken in storage drive and processed in the software Finch TV. The electropherogram files which were in AB1 format was converted to. pdf and fasta files using a Sequence Scanner Software. The sequence data generated during this study were subjected of BLAST searches in the nucleotide database of GenBank (http://blast.ncbi.nlm.nih.gov/) to determine their most probably closely related taxa.
Isolation of endophytic fungi from Moringa oleifera
The Moringa oleifera leaf samples were washed thoroughly under running tap water for 10 min to remove the superficial debris adhered and finally washed with double distilled water to minimize the microbial load from the sample surface. The surface treatment is done and the epiphytic mycelia are removed by immersing the tissues in 70% ethanol for 1–3 min and in an aqueous solution of sodium hypochlorite (4% available chlorine) for 2–5 min followed by washing with 70% ethanol for 5s. The tissues are then rinsed in sterile distilled water and were allowed to surface dry in sterile conditions. The leaves were carefully dissected into small pieces (1.0 · 0.5 cm). The pieces were placed on petri dishes containing potato dextrose agar (PDA) medium and incubated for seven days at 25±2 °C in the incubator. Tissues were observed for fungal growth at 2 d intervals for seven days. The actively growing fungal tips that are emerging from plant tissues were subcultured on PDA Petri plates for identification.
Isolation of DNA from endophytic fungi
Genomic DNA was extracted from pure fungal cultures and was named as a black colony (Bc) and grey colony (Gc) by using the CTAB method followed by column purification. Polymerase chain reaction (PCR) was used to amplify partial gene regions of Internal Transcribed Spacers (ITS) using fungal primers such as ITS2 AND ITS4. PCR amplification were acted in total reaction volume of 25 μl containing 12.5 μl of 2X PCR Master mix, 1 μl of forward primer and 1 μl of reverse primer and 9.5 μl of nuclease-free water. DNA amplification was performed and DNA thermal cycler programmed for 35 cycles, the first step involved is heating to a temperature of 95 °C for 5 min trailed by 35 amplification cycles at 75 °C for 1 min for denaturation. The process of annealing will take place in, 53 °C about 1-2 min. The temperature involved is 72 °C for 1 min for initial extension and Taq polymerase starts filling the missing nucleotides in the 3’ 5’ direction away from each of the primer and 72 °C for 8 min for final extension. The quality of PCR products was checked on 1 % agarose gel electrophoresis stained with ethidium bromide. The Purification and sequencing of PCR products are carried in Sequencer-Applied Biosystems (Hitachi)-3130x1 Genetic Analyzer.
Estimation of flavonoids
Shinoda test
1 ml of absolute ethanol and 3 drops of concentrated hydrochloric acid were added to 0.5 ml of diluted plant or fungal crude extract in isopropyl alcohol. Formation of red colour indicated the presence of aurones and chalcones. In cases where no colour change was observed, pieces of metallic magnesium were added. The formation of orange, red or magenta coloration indicated the presence of flavones or flavonoids, respectively [12].
Estimation of terpenoids
2.0 ml of chloroform was added with the 5 ml aqueous fungal crude extract or plant ethanol extract is taken and evaporated on the water path and then boiled with 3 ml of H2SO4 concentrated. A grey colour formed which showed the entity of terpenoids [12].
RESULTS AND DISCUSSION
DNA was isolated by using CTAB method. After the isolation of DNA, the quantity and quality of DNA was checked with the help of Gel electrophoresis. The isolated DNA was subjected to electrophoresis and the gel will be run for getting specific region of DNA. After the process of gel electrophoresis, the gel has been removed and it was observed under UV light by comparing it with the standard IKB ladder as obtained in fig. 3. The ITS regions of DNA were amplified using polymerase chain reaction using matK and ITS2 primers for plant and ITS2, ITS4 primers for endophytic fungi respectively where it produced a proper band and the obtained products have been gel purified for obtaining a pure template for sequencing and compared it with 1KB standard ladder as obtained in fig. 4. The sequencing files are obtained in AB1 format which can be viewed by using software Finch TV as electropherogram peaks of different nucleotides in its position.

Fig. 3: DNA isolated from Moringa leaves and Endophytic fungi and compared with standard 1KB ladder

Fig. 4: Amplification of plant genes ITS2 and Matk, along with amplification of fungal gene ITS
Quality of the obtained sequence can be observed through Electropherogram peaks as seen in fig. 5. FASTA sequences for further analysis were obtained by converting AB1 file in Seq Scanner 2.0. Using BLAST server, unknown sequences were identified based on query coverage, percentage identity and e-value. When the FASTA file of this Moringa Mat K and Moringa ITS2 has shown nearly 98% similarity, whereas black moringa fungi and moringa green fungi has shown nearly 97% in NCBI blast as shown in table 3.
The results from Finch TV. ab1 format is converted to. pdf and fasta format. These fasta sequences are then used for constructing the phylogenetic tree using Clustal Omega as shown in fig. 6, 7 was done to find out the evolutionary relationship of our query sequence, representative trees.

Fig. 5: Representative electropherogram showing the sequenced genes
Fasta sequences of plant genes
>ML_ITS2_E12. ab1
TTACGTTCAGCTGCATCTGTCAGTCACGCTTCCTGTGCGCTTATGTACCTCCGAAGCCTCCGCGGGCGCGCCGTTGCCTGCCGCTACGGGGCATCTCAATGAATGGTAACAAATGTAATCATGGTCTTGACAGACCCTAAAAAGTTAATACAACTTTCGACAACGGATCTCTTGGCTCTCGCATCGATGAAGAACGCAGCGAAATGCGATAAGTAATGTGAATTGCAGAATTCAGTGAATCATCGAATCTTTGAACGCACCTTGCGCCCTTTGGTATTCCGAGGGGCATGCCTGTTTGAGTGTCATTAAATACCATCAACCCTCTTTTGACTTCGGTCTCGAGAGTGGCTTGGAAGTGGAGGTCTGCTGGAGCCTAACGGAGCCAGCTCCTCTTAAATGTATTAGCGGATTTCCCTTGCGGGATCGCGTCTCCGATGTGATAATTTCTACGTCGTTGACCATCTCGGGGCTGACCTAGTCAGTTTCAATAGGAGTCTGCTTCCAACCGTCTCTTGACCGAGACTAGCGACTTGTGCGGTGACTTTTGACTTGACCTCAAATCAGGTAGGACTACCCGCTGAACTTAAGCATATCAATAAGCGGGGGGAAGCCAGCCGTCCCGGAAGGAGTACCCCCCCAATACTTAAGAGAGAGAGTAGGTCGCAAAAAACGAAAAGGAGACCAC.
>ML_Matk_E12. ab1
GTTCAGCTGCATCTGTCAGTCACGCTTCCTGTGCGCTTATGTACCTCCGAAGCCTCCGCGGGCGCGCCGTTGCCTGCCGCTACGGGGCATCTCAATGAATGGTAACAAATGTAATCATGGTCTTGACAGACCCTAAAAAGTTAATACAACTTTCGACAACGGATCTCTTGGCTCTCGCATCAATCTTTGAACGCACCTTGCGCCCTTTGGTATTCCGAGGGGCATGCCTGTTTGAGTGTCATTAAATACCATCAACCCTCTTTTGACTTCGGTCTCGAGAGTGGCTTGGAAGTGGAGGTCTGCTGGAGCCTAACGGAGCCAGCTCCTCTTAAATGTATTAGCGGATTTCCCTTGCGGGATCGCGTCTCCGATGTGATAATTTCTACGTCGTTGACCATCTCGGGGCTGACCTAGTCAGTTTCAATAGGAGTCTGCTTCCAACCGTCTCTTGACCGAGACTAGCGACTTGTGCGGTGACTTTTGACTTGACCTCAAATCAGGTAGGACTACCCGCTGAACTTAAGCATATAATAAGCGGGGGGAAGCCAGCCGTCCCGGAAGGAGTACCCCCCCAATACTTAAGAGAGAGAGTAGGTCGCAAAAAACGAAAAGGAG.
Table 1: table showing the presence of endophytic fungi in the different medicinal plants. As each and every plant shows the presence of different kinds of endophytic fungi that has a symbiotic relationship with plant that does not cause any harm to plant and provides different kinds of properties to the plant.
The presence of Fungal Black colony and green colony was grown in PDA Media (fig. 8). The identification of fungal endophytes was done by Lactophenol cotton blue staining. DNA was extracted using CTAB Method. The ITS2 primers were used in PCR to amplify the ITS region. The obtained PCR products were then gel purified for getting a pure template for Sanger gene sequencing. After Sanger gene sequencing the obtained results were converted to FASTA sequences. These fasta sequences were then used for constructing the phylogenetic tree using Clustal Omega as shown in (fig. 9, 10.)
Table 1: Table showing the presence of endophytic fungi in the different medicinal plants
| S. No. | Plant name | Endophytic fungi | Studies | Reference |
| 1. | Antidesma madagascariense | Fusarium oxysporumcepae, Pestalotiopsis microspore, Neofusicoccum parvum, Guignardiamangifera, Cyphomyrmexmuelleri, Penicillium westlingii, Penicillium griseofulvum | PDA Media, DNA sequence analysis, and Phylogenetic Data Analysis | [13] |
| 2. | Actinidia macrosperma | Acremonium furcatum, Cylindrocarponpauciseptatum, Trichoderma citrinoviride, Paecilomycesmarquandii, Chaetomium globosum | PDA Media, Morphological examination, Phylogenetic analysis. | [14] |
| 3. | Butea monosperma | Fusarium solani, Fusarium sterilihyphosum, Pithomyceschartarum, Fusarium verticillioides | Richard solution, Conidial germination assay | [15] |
| 4. | Costus spiralis | Diaporthephaseolorum, Sordariomycetes sp, Phomopsis sp., Cochliobolusssp | PDA media, DNA Amplification and screening. | [16] |
| 5. | Artemisia sieberi | Aspergillus oryzae, Aspergillus niger, Peniciliumchrysogenum | SDA medi, 18S rRNA Gene Sequencing, Phylogenetic analysis. | [17] |
| 6. | Morinda citrifolia | Stemphylium solani, Leptosphaerulina australis, Aspergillus pseudodeflectus, Paraconiothyriumsporulosum | PDA, Amplification, Sequencing. | [18] |
| 7. | Mikania cordata | Fusarium equiseti, Phomamedicaginis | PDA Media, DNA Amplification, and screening | [19] |
| 8. | Cymbopogon caesius | Curvularialunata. | PDA Media, Amplification, Phylogenetic analysis | [20] |
| 9. | Carica papaya | Daldiniaeschscholtzii | PDA Media, morphological and molecular identification. | [21] |
| 10. | Tridax procumbens | Daldiniaplacentiformis, Alternaria alternata | PDA Media, Morphological and Molecular identification. | [21] |
| 11. | Coscinium fenestratum | Phomopsis jacquiniana, Alternaria alternata, Aspergillus tamarii, Aspergillus fumigatus, Drechslera | PDA Media, Sub culturing, Statistical Analysis | [22] |
| 12. | Phyllanthus acidus | Phyllostictasp, Phomopsis Sp, Curvularialunata, Pestolotiopsis | PDA Media, Morphological Examination, Statistical Analysis | [23] |
| 13. | Catharanthus roseus | Colletotrichum Sp., Macrophominaphaseolina, Nigrosporasphaerica and Fusarium solan | PDA Media, Morphological examination, Statistical analysis | [23] |
| 14. | Azadirachta indica | Aspergillus fumigates, Cladosporium cladosporioides, Chaetomium globosum, Aspergillus niger, Alternaria alternata | PDA Media, Morphological examination, Statistical analysis | [24] |
| 15. | Ephedra pachyclada | Penicillium crustosum, Penicillium commune, Alternaria infectoria, Alternaria tenuissima, Penicillium corylophilum | Malt Extract Agar medium, Molecular identification, Phylogenetic analysis | [25] |
| 16. | Artemisia scoparia | Penicillium melinii, Alternaria alternate, Gliocladiumsolani, Trichoderma longibrachiatum Trichoderma virens, Aspergillus versicolor |
PDA media, Morphological identification, Statistical Analysis | [26] |
| 17. | Dendrobium moniliforme | Cladosporium tenuissimum, Colletotrichum alatae Cylindrocarpon, Fusarium equiseti, Leptosphaerulinachartarum, Trichodermharzianum |
PDA media, DNA Amplification, Morphological Identification Sequencing, |
[27] |
| 18. | Helicteres isora | Alternaria alternate, Penicillium citrinum, Aspergillus niger, Curvulariavermiformis | PDA media, Morphological Identification, Statistical Analysis | [28] |
| 19. | Oryza sativa | Aspergillus terreus, Fusarium solani, Aspergillus flavus, Chaetomium cupreum, Curvularialunata, Chaetomium brasilense | PDA Media, DNA Amplification, Sequencing, Phylogenetic Analysis. | [29] |
| 20. | Curcuma longa | Aspergillus venenatus, Fusarium proliferatum, Trichoderma asperellum, Phomaherbarum, Trichoderma atroviride | PDA Media, DNA Amplification, Phylogenetic analysis | [30] |
| 21. | Portulaca oleracea | Fusarium oxysporum, Penicillium ochrochloron, Chaetomium globosum, Penicillium citreonigrum, Petriella sordid | PDA Media, DNA Amplification, Morphological Identification. | [31] |
| 22. | Warburgia ugandensis | Nigrosporaoryzae, Cladosporium bruhnei, Colletotrichum acutatum, Cochliobolus sativus, Bionectriaochroleuca, Phyllostictagardeniicola | PDA Media, DNA Amplification, Morphological Identification, Sequencing. Phylogenetic Analysis | [32] |
| 23. | Cephalotaxus hainanensis | Alternaria tenuissima, Bionectriaochroleuca, Diaporthe helianthin, Lasiodiplo-dia Theobroma, Phomopsis quercella, Trametespolyzona | PDA Media, DNA Amplification, Statistical Analysis | [33] |
| 24. | Sesbania grandiflora | Fusarium oxysporum, Hormisciumsp, Penicillium citreonigrum | PDA Media, Morphological Identification | [34] |
| 25. | Terminalia chebula | Alternaria longipes, Curvularialunata, Aspergillus flavus, Aspergillus niger | PDA Media, Morphological and Molecular Identification, Statistical Analysis | [35] |
| 26. | Messua ferrea | Aspergillus flavus, Aspergillus versicolo A. sydowii |
PDA Media, Morphological and Molecular Identification, Statistical Analysis | [36] |
| 27. | Crescentia Cujete L. | Nigrosporasphaerica Fusarium oxysporum Gibberella moniliformis , Beauveria bassiana | PDA Media, Morphological Identification, Statistical Analysis | [37] |
| 28. | Psidium guajava | Rhizopus arrhizus, Candida albicans, Epidermophytumfloccosum, Aspergillus niger, Mucor circinelloides Lichtheimiacorymbifer | MacConkey and nutrient agar, Morphological and Molecular Identification, | [38] |
| 29. | Jatropha curcas | Fusarium proliferatum, Guignardia camelliae, Alternaria destruens, Colletotrichum truncatum, Nigrospora oryzae | PDA Media, DNA Amplication, PCR and Sequencing | [39] |

Fig. 6: Phylogenetic tree showing relationship of query sequence of ITS2 from Moringa oleifera obtained using clustal omega

Fig. 7: Phylogenetic tree showing relationship of query sequence of Mat K from Moringa oleifera obtained using clustal omega
Fig. 8: Endophytic fungi (Black fungi and green fungi)

Fig. 9: Phylogenetic tree showing relation of Aspergillus fumigatus strain obtained using Clustal Omega

Fig. 10: Phylogenetic tree showing relation of Trichoderma turrialbensestrain obtained using Clustal Omega
Table 2: Table showing hits obtained and similarity percentage for the query sequences in NCBI BLAST
| S. No. | Sample name | Hit obtained | Accession number | Percentage similarity |
E-value | Query coverage |
| 1 | Moringa ITS2 | Moringa oleifera ribulose-1,5-bisphosphate carboxylase/oxygenase large subunit | JX091932.1 | 98% | 0.0 | 82% |
| 2 | Moringa Matk | Moringa oleifera chloroplast matK gene for maturase K, partial cds | LC547438.1 | 97% | 0.0 | 85% |
| 3 | Moringa BF ITS | Aspergillus fumigatus Af293 chromosome 3, whole genome shotgun sequence | CM000171.1 | 96% | 0.0 | 92% |
| 4 | Moringa GF ITS | Trichoderma turrialbense strain CBS 112445 18S ribosomal RNA gene, partial sequence; internal transcribed spacer 1, 5.8S ribosomal RNA gene | EU330945.1 | 98% | 0.0 | 91% |
There are so many species of endophytic fungi that produce a different kind of enzymes such as cellulase, amylases, lipases, laccase, pectinases, xylanase, and proteases as shown in TABLE 3, that are used in biological activity and also in industrial applications, it also helps the plant to produce different kinds of secondary metabolites that helps in plant growth and also gives different kind of properties such as antioxidant, antimicrobial, antidiabetic to the plant. Secondary metabolites synthesised by endophytes isolated from Moringa oleifera also displayed presence of flavonoids and terpenoids, the presence of these compounds provide anti-fungal, antioxidant properties as shown in table 4.
Table 3: Table showing different kinds of Enzymes produced by endophytic fungi
| S. No. | Enzymes | Endophytic fungi | References |
| 1. | Cellulase | Penicillium sp, Phoma sp, Paraconiothyrium sp, Nigrosporasphaerica, Cladosporium cladosporioides, Asperigillus japonicus | [40] |
| 2. | Amylases | Fusarium sp, Penicillium sp, Lasiodiplodia sp, Paraconiothyrium sp, Fusicoccum sp, Xylaria sp | [41] |
| 3. | Lipases | Fusarium sp, Xylaria sp, Phomopsis sp, Phoma sp, Penicillium sp, Fusicoccum sp, Diaporthe sp, Cercospora sp, Colletotrichum sp, Nigrospora sp, Paraconiothyrium sp, Pestalotiopsis sp, Guignardia sp |
[42, 44] |
| 4. | Laccase | Fusarium sp, Xylaria sp, Pestalotiopsis sp, Chaetomium globosum | [43, 45] |
| 5. | Pectinase | Aspergillus japonicus, Penicillium glandicola | [46] |
| 6. | Xylanase | Aspergillus sp, Penicillium sp, Trichoderma sp, Fusarium sp, Rhizopus sp, Cladosporium sp, Nigrospora sp, Myrothecium sp | [47, 49] |
| 7. | Protease | Phomatropica, Trichoderma aristate, Asperigillus terricola, Asperigillus japonicus, Fusarium lateritium | [50, 51] |
Table 4: table showing the presence of secondary metabolites produced by both the Moring oleifera and also from the endophytic fungi (Black Fungi, Green Fungi) that are been isolated from the plant that gives the plant different properties.
Table 4: Table showing results of qualitative test conducted for flavonoids and terpenoids
| S. No. | Sample name | Flavonoids | Terpenoids |
| 1 | Moringa ITS2 | Present | Present |
| 2 | Moringa Matk | Present | Present |
| 3 | Moringa BF ITS | Partially present | Partially present |
| 4 | Moringa GF ITS | Present | Present |
From this study Moringa oleifera has shown the presence of two endophytic fungi. The ITS sequences identified as Aspergillus fumigatus and Trichoderma turrialbense. The current study showed that the endophytic fungi isolated from Moringa oleifera has potential for the production of enzymes such as Lipases, Proteases, Cellulases that helps fungi in producing different kinds of secondary metabolites such as Flavonoids, Terpenoids that gives the plant different properties such as antimicrobial, anti-oxidant. The further studies can be done for checking the presence of other secondary metabolites and also for identifying other Endophytic species.
CONCLUSION
The Endophytic fungus Aspergillus fumigatus and Trichoderma turrialbense were isolated from the medicinal plant Moringa oleifera. From the ethanol extract, it has shown the presence of secondary metabolites such as Flavonoids, Terpenoids. The production of different kinds of enzymes such as cellulase, xylanase, pectinase etc., from endophytic fungi has given the plant different kinds of properties. Since last many years, endophytic fungi were addressing new source of pharmacologically dynamic secondary metabolites in light of the basic presumption that they live advantageously inside their host plant. To distinguish clear bioactive mixtures, various techniques must be created in the future to separate leftover optional metabolites from plant endophytic organisms and furthermore for the recognizable proof of various types of enzymes produced by endophytic fungi.
ACKNOWLEDGEMENT
Priyanka has executed the research. Dr. Shruthi S. D has guided in carrying out the project and framing the research article. Dr. Shobha is a botanist who has authenticated the plant species.
FUNDING
Nil
AUTHORS CONTRIBUTIONS
All the authors have contributed equally.
CONFLICT OF INTERESTS
Declared none
REFERENCES
-
Yeoh H. Food value of lesser utilised tropical plants. Food Chem. 1993;46(3):239-41. doi: 10.1016/0308-8146 (93) 90113-T.
-
Dillard CJ, German JB. Phytochemicals: nutraceuticals and human health. J Sci Food Agric. 2000;80(12):1744-56. doi: 10.1002/1097-0010(20000915)80:12<1744::AID-JSFA725>3.0.CO;2-W.
-
Siddhuraju P, Becker K. Antioxidant properties of various solvent extracts of total phenolic constituents from three different agroclimatic origins of drumstick tree (Moringa oleifera Lam.) leaves. J Agric Food Chem. 2003;51(8):2144-55. doi: 10.1021/jf020444+, PMID 12670148.
-
Morimitsu Y, Hayashi K, Nakagawa Y, Horio F, Uchida K, Osawa T. Antiplatelet and anticancer isothiocyanates in Japanese domestic horseradish, wasabi. Biofactors. 2000;13(1-4):271-6. doi: 10.1002/biof.5520130141, PMID 11237193.
-
Clay K, Schardl C. Evolutionary origins and ecological consequences of endophyte symbiosis with grasses. Am Nat. 2002;160Suppl 4:S99-S127. doi: 10.1086/342161, PMID 18707456.
-
Wilson D. Ecology of woody plant endophytes. In: Microbial endophytes. Marcel Dekker; 2000.
-
Rosenblueth M, Martínez Romero E. Bacterial endophytes and their interactions with hosts. Mol Plant Microbe Interact. 2006;19(8):827-37. doi: 10.1094/MPMI-19-0827, PMID 16903349.
-
Strobel G, Daisy B. Bioprospecting for microbial endophytes and their natural products. Microbiol Mol Biol Rev. 2003;67(4):491-502. doi: 10.1128/MMBR.67.4.491-502.2003, PMID 14665674.
-
Wilson D. Endophyte: the evolution of a term, and clarification of its use and definition. Oikos. 1995;73(2):274-6. doi: 10.2307/3545919.
-
Clay K. Fungal endophytes of grasses: a defensive mutualism between plants and fungi. Ecology. 1988;69(1):10-6. doi: 10.2307/1943155.
-
Dhananjaiah TM, Chatterjee S, Chandrika S, Tanthry SSD. DNA barcoding of Cynadon Dactylon and molecular characterization of its endophytic fungi. Int J Sci Eng Mang. 2020;5(7):22-9.
-
Bhardwaj A, Sharma D, Jodan N, Agrawal PK. Antimicrobial and phytochemical screening of endophytic fungi isolated from spikes of Pinus roxburghii. Arch Clin Microbiol. 2015;6(3: 1):1-9.
-
Jeewon R, Ittoo J, Mahadeb D, Jaufeerally Fakim Y, Wang HK, Liu A. DNA-based identification and phylogenetic characterisation of endophytic and saprobic fungi from antidesma madagascariense, a medicinal plant in mauritius. J Mycol. 2013;2013:1-10. doi: 10.1155/2013/781914.
-
Lu Y, Chen C, Chen H, Zhang J, Chen W. ’Isolation and identification of endophytic fungi from Actinidia macrosprema and investigation of their bioactivities. Evd Based Complement Alternat Med. 2011;2011:1-8.
-
Tuppad DS, Shishupala S. Evaluation of endophytic fungi from Butea monosperma for antimicrobial and enzyme activity. J Med Plants Stud. 2014;2(4):38-45.
-
Marson Ascencio PGM, Ascencio SD, Aguiar AA, Fiorini A, Pimenta RS. Chemical assessment and antimicrobial and antioxidant activities of endophytic fungi extracts isolated from Costus spiralis (Jacq.) roscoe (Costaceae). Evid Based Complement Alternat Med. 2014;2014:190543. doi: 10.1155/2014/190543, PMID 25587339.
-
Ibtisam A, Ababutain S, Aljuraifani A, Alghamdi A, Alabdalall A, Al-Khaldi E. Identification and antibacterial characterization of endophytic fungi from Artemisia sieberi. Int J Microbiol. 2021;12:1-11.
-
Yougen W, Sisay G, Vitor M, Da S, Brian P, Xinwen H. The role of endophytic fungi in the anticancer activity of Morinda citrifolia linn. (Noni). Evd Based Complement Alternat Med. 2015;2015:1-8.
-
Jayatilake PL, Munasinghe H. Antimicrobial activity of cultivable endophytic and rhizosphere fungi associated with “Mile-a-Minute,” Mikania cordata (Asteraceae). Biomed Res Int. 2020;2020:5292571. doi: 10.1155/2020/5292571, PMID 32626746.
-
Avinash KS, Ashwini HS, Babu HNR, Krishnamurthy YL. Antimicrobial potential of crude extract of curvularia lunata, an endophytic fungi isolated from Cymbopogon caesius. J Mycol. 2015;2015(2):1-4. doi: 10.1155/2015/185821.
-
Rashmi M, Kushveer JS, Mohd I, Sarma V. Evaluation of antioxidant potential, DNA damage protection and anticancer activities of three endophytic fungi associated with selected medicinal plants. Int J Pharm Biol Sci. 2019;9(2):1174-84.
-
Goveas S, Madtha Royston NS, D’Souza L. Isolation of endophytic fungi from Coscinium fenestratum (Gaertn.) colber. A red-listed endangered medicinal plant. Bulg J Agric Sci. 2011;17(6):767-72.
-
Manogaran S, Kannan KP, Mathiyalagan Y. Fungal endophytes from Phyllanthus acidus (L.) and Catharanthus roseus (L.). Int Res J Pharm. 2017;8(10):86-9. doi: 10.7897/2230-8407.0810186.
-
Qureshi AH, Shok I, AK Pandey. Isolation and identification of endophytic fungi inhabiting Azadirachta indica A. Juss. From different regions of Jabalpur (M. P) India. Res J Life Sci Bioinform Pharm Chem Sci. 2019;5(3):274-81.
-
Khalil MA, Saad H, Sultan A, Eid Ahmed EE, Azab Ehab, Gobouri Adil, Elkelish Amr, Fouda Amr. Isolation and characterization of fungal endophytes isolated from medicinal plant Ephedra pachyclada as plant growth-promoting. Biomolecules. 2021;11(2)140:1-19.
-
Nisa H, Kamili AN, Nawchoo IA, Skinder Bhat Mohd, Ruqeya Nazi. Isolation and identification of endophytic fungi from Artemisia scoparia (Asteraceae). I J Theor App Sci. 2018;10(1):83-8.
-
Sujit S, Roshani S, Sabitri M, Marc SA, Bijaya P. Isolation and characterization of plant growth-promoting endophytic fungi from the roots of Dendrobium moniliforme. Plants J. 2018;8(5):1-11.
-
Gayathri Pai CM. Screening of phytochemicals and isolation of endophytic fungi from medicinal plant Helicteres isora L. J Pharmacol. 2017;7(12):1-5.
-
Leewijit T, Pongnak W, Soytong K, Poeaim S. Isolation of soil and endophytic fungi from rice (Oryza sativa L.). Int J Agric Technol. 2010;12(7.2):2191-202.
-
Kazi F, Farhana A, Islam Md, Mazid Md, Mohammad S. Isolated endophytic fungi from the plant Curcuma longa and their potential bioactivity a review. J Pharm Pharmacol. 2019;10:244-70.
-
Zhang Y, Wan Y, Tie Y, Zhang B, Wang R. Isolation and characterization of endophytic fungi from purslane and the effects of isolates on the growth of the host. AiM. 2019;09(5):438-53. doi: 10.4236/aim.2019.95026.
-
Mirriam M, Wanjiru W, Mourine K, Christine Bii, Muthumbi A, Charles K. Isolation and characterization of endophytic fungi from medicinal plant Warburgia ugandensis. J Biol Agric Healthc. 2018;8(12):57-66.
-
Yang HR, Hu XP, Jiang CJ, Qi J, Wu YC, Li W. Diversity and antimicrobial activity of endophytic fungi isolated from Cephalotaxus hainanensis Li, a well-known medicinal plant in China. Lett Appl Microbiol. 2015;61(5):484-90. doi: 10.1111/lam.12483, PMID 26280451.
-
Nurhidayat A, Noviany N, Setiawan Andi Setiawan A. Isolation and identification of endophytic fungi associated with Indonesian Sesbania grandiflora plant. J Phys: Conf Ser. 2021;1751(1):1-6. doi: 10.1088/1742-6596/1751/1/012093.
-
Rajeswari Rajeswari, R Revathi, Prasanth D, Rajeswari R, RR, D AP. Isolation and identification of endophytic fungi from Terminalia chebula of eastern ghats, TamilnNadu. Asian J Pharm Clin Res. 2017;10(4):21. doi: 10.22159/ajpcr.2017.v10i4.15507.
-
Dwi H, Risda S, Asmiyenti D, Retno W. Isolation, identification, phytochemical screening, and antibacterial activity of Aspergillus sp. MFD-01, an endophytic fungus derived from Mesua ferrea. Pharmaciana. 2018;8(2):331-8.
-
Seetharaman Prabu Kumar SP, Kuberan Raj K, Ravindran Keppanan, Sivaramakrishnan SS. Isolation and characterization of endophytic fungi from medicinal plant Crescentia cujete l. and their antibacterial, antioxidant and anticancer properties and their antibacterial, antioxidant and anticancer properties. Int J Pharm Pharm Sci. 2015;7(11):316-21.
-
Lawal G, Hamza A, Adamu ZY, Muhammed I, Adamu MT, Aisami A. Isolation and evaluation of in vitro antibacterial potential of endophytic fungi from the leaves of Psidium guajava (Guajava). Bayero J Pure Appl Sci. 2020;13(1):20-4.
-
Kumar Susheel K, Kaushik Nutan K. Endophytic fungi isolated from oil-seed crop Jatropha curcas produces oil and exhibit antifungal activity. PLOS One. 2013;8(2):1-8.
-
Krogh Kristian, Mørkeberg Astrid, Jørgensen Henning, Frisvad Jens, Olsson LisbethKrogh KB, Mørkeberg A, Jørgensen H, Frisvad JC, Olsson L. Screening Ggenus Penicillium for producers of cellulolytic and xylanolytic enzymes. Appl Biochem Biotechnol. 2004;113-116:389-401. doi: 10.1385/abab:114:1-3:389, PMID 15054266.
-
Venkatesagowda B, Ponugupaty E, Barbosa AM, Dekker RFH. Diversity of plant oil seed-associated fungi isolated from seven oil-bearing seeds and their potential for the production of lipolytic enzymes. World J Microbiol Biotechnol. 2012;28(1):71-80. doi: 10.1007/s11274-011-0793-4, PMID 22806781.
-
Hala MOR, Adel AE, Hassaan AE, Samed AD. Production, optimization and partial purification of lipase from Fusarium oxysporum. J Appl Sci Environ Sanitation. 2010;5:39-53.
-
Sunitha VH, Devi ND, Srinivas C. Extracellular enzymatic activity of endophytic fungal strains isolated from medicinal plants. World J Agric Sci. 2013;9(1):1-9.
-
Katoch M, Aseem S, Gurpreet S, Katoch M, Salgotra A, Singh G. Endophytic fungi found in association with Bacopa monnieri as potential producers of industrial enzymes and antimicrobial bioactive compounds. Braz Arch Biol Technol. 2014;57(5):714-22. doi: 10.1590/S1516-8913201402502.
-
El-Zayat SA. Preliminary studies on laccase production by Chaetomium globosum an endophytic fungus in Glinus lotoides. Am Eurasian J Agric Environ Sci. 2008;3:86-90.
-
Teixeira MFS, Lima Filho JL, Duran N. Carbon sources effect on pectinase production from Aspergillus japonicus 586. Braz J Microbiol 2020;31(4). doi: 10.1590/S1517-83822000000400009.
-
Saha BC. Production, purification and properties of xylanase from a newly isolated Fusarium proliferatum. Process Biochem. 2002;37(11):1279-84. doi: 10.1016/S0032-9592(02)00012-2.
-
Goulart AJ, Carmona EC, Monti R. Partial purification and properties of cellulase-free alkaline xylanase produced by Rhizopus stolonifer in solid-state fermentation. Braz Arch Biol Technol. 2005;48(3):327-33. doi: 10.1590/S1516-89132005000300001.
-
Butt MS, Tahir Nadeem M, Ahmad Z, Sultan MT. Xylanases and their applications in the baking industry. Food Technol Biotechnol. 2008;46:22-31.
-
Braz SCM, Souza Motta CM, Lima DMM, Neves RP, Magalhaes OMC, Braz SC, Motta CM, Massa DM, Neves RP, Magalhaes OM. Viability, taxonomic confirmation and enzymatic detection of Acremonium species preserved under mineral oil in the URM culture collection. Rev Soc Bras Med Trop. 2009;42(1):63-6. doi: 10.1590/s0037-86822009000100013, PMID 19287938.
-
Vishwanatha KS, RAppurao A, Singh SA. Characterization of acid protease expressed from Aspergillus oryzae MTCC 5341. Food Chem. 2009;114(2):402-7. doi: 10.1016/ j.foodchem.2008.09.070.